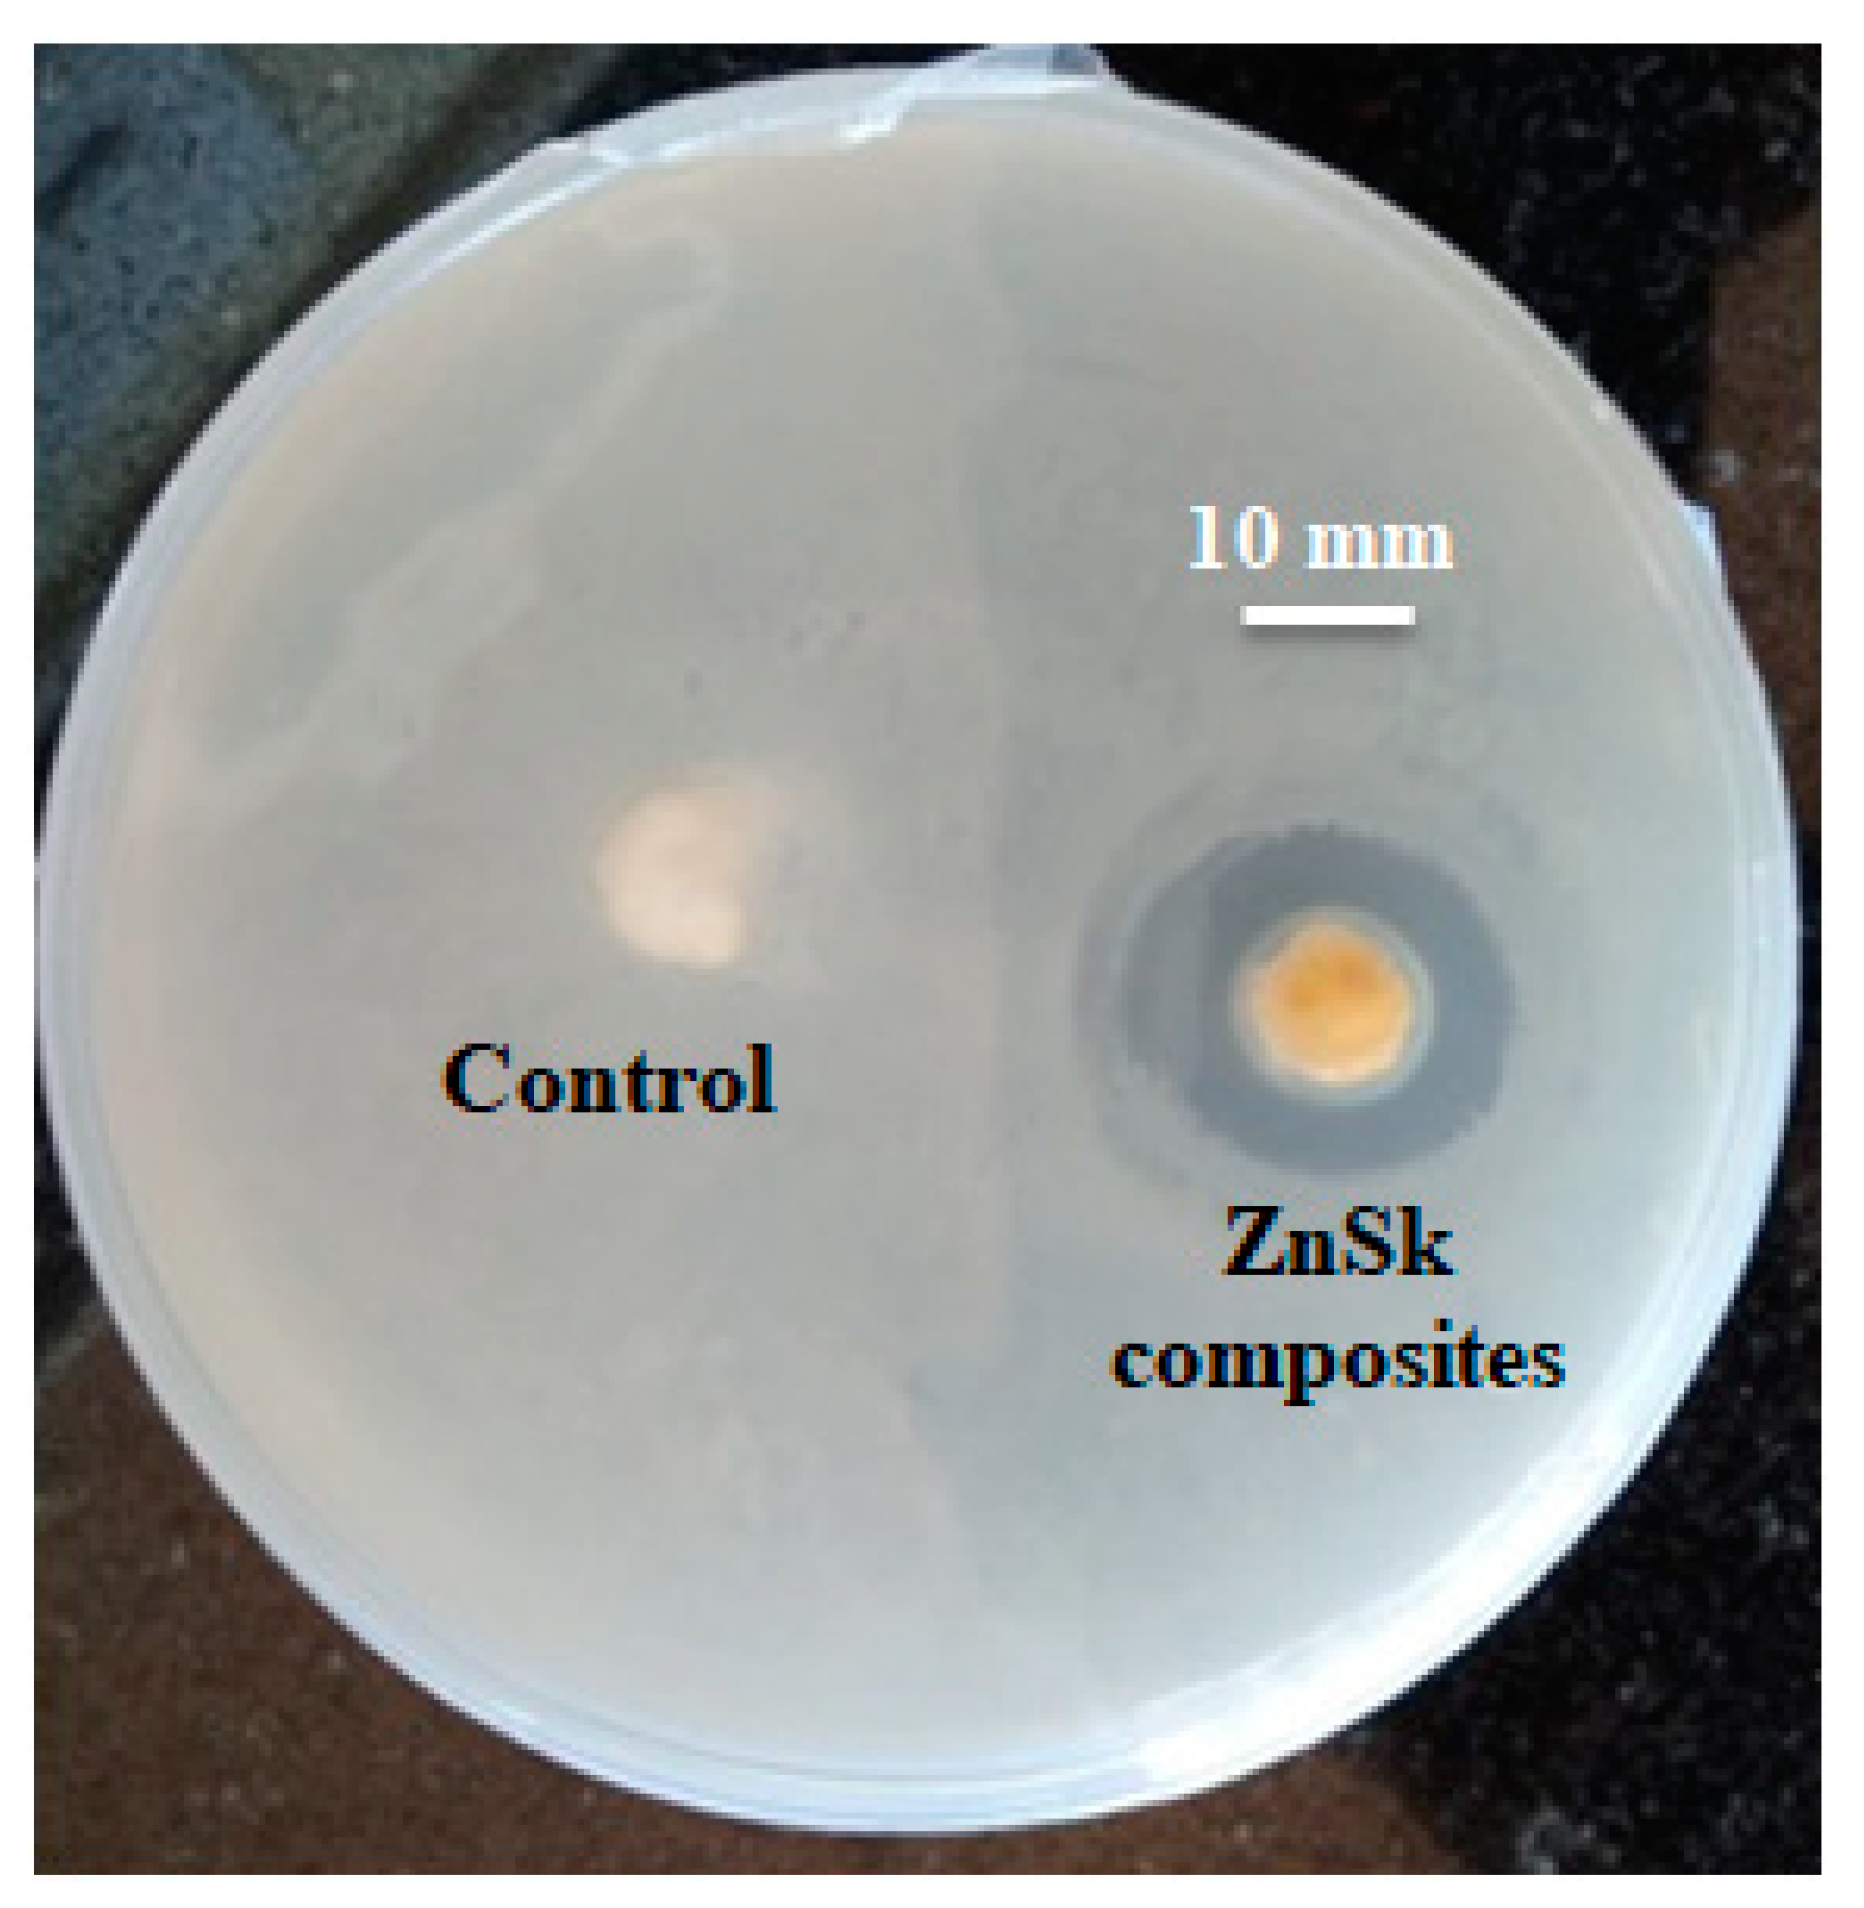
Polymers 12 01151 g007 Polymers 12 01151 g007

Development of ZnO Nanoflake Type Structures Using Silk Fibres as Template for Water Pollutants Remediation
Abstract
1. Introduction
2. Materials and Methods
2.1. Degumming Step
2.2. Synthesis of ZnO Nanoflakes on Silk Fibres (ZnSk)
2.3. Catalytic Study
2.4. Rose Bengal (RB) Dye Removal
2.5. Antimicrobial Activity of ZnSk Composite
2.6. Analysis and Characterization
3. Results
3.1. Microscopic Analysis
3.2. XRD Analysis
3.3. UV-Vis Spectroscopy Analysis
3.4. Degradation Study
3.5. RB Removal/Adsorption Study
3.6. Antimicrobial Activity of ZnO Composites
4. Conclusions
Author Contributions
Funding
Acknowledgments
Conflicts of Interest
References
- Park, K.-H.; Han, G.D.; Neoh, K.C.; Kim, T.-S.; Shim, J.H.; Park, H.-D. Antibacterial activity of the thin ZnO film formed by atomic layer deposition under UV-A light. Chem. Eng. J. 2017, 328, 988–996. [Google Scholar] [CrossRef]
- Lian, X.; Li, Y.; An, D.; Zou, Y.; Wang, Q.; Zhang, N. Synthesis of porous ZnO nanostructures using bamboo fibers as templates. Mater. Sci.-Pol. 2014, 32, 514–520. [Google Scholar] [CrossRef]
- Umar, A.; Hahn, Y.-B. (Eds.) Metal Oxide Nanostructures and Their Applications; Nanotechnology book series; American Scientific Publ.: Los Angeles, CA, USA, 2010. [Google Scholar]
- Khin, M.M.; Nair, A.S.; Babu, V.J.; Murugan, R.; Ramakrishna, S. A review on nanomaterials for environmental remediation. Energy Environ. Sci. 2012, 5, 8075–8109. [Google Scholar] [CrossRef]
- Samadi, M.; Zirak, M.; Naseri, A.; Kheirabadi, M.; Ebrahimi, M.; Moshfegh, A.Z. Design and tailoring of one-dimensional ZnO nanomaterials for photocatalytic degradation of organic dyes: A review. Res. Chem. Intermed. 2019, 45, 2197–2254. [Google Scholar] [CrossRef]
- Szatkowski, T.; Siwińska-Stefańska, K.; Wysokowski, M.; Stelling, A.L.; Joseph, Y.; Ehrlich, H.; Jesionowski, T. Immobilization of Titanium(IV) Oxide onto 3D Spongin Scaffolds of Marine Sponge Origin According to Extreme Biomimetics Principles for Removal of C.I. Basic Blue 9. Biomimetics 2017, 2, 4. [Google Scholar] [CrossRef]
- Unterlass, M.M. Geomimetics and Extreme Biomimetics Inspired by Hydrothermal Systems—What Can We Learn from Nature for Materials Synthesis? Biomimetics 2017, 2, 8. [Google Scholar] [CrossRef]
- Ehrlich, H. (Ed.) Extreme Biomimetics; Springer International Publishing: Cham, Switzerland, 2017. [Google Scholar]
- Wysokowski, M.; Motylenko, M.; Beyer, J.; Makarova, A.; Stöcker, H.; Walter, J.; Galli, R.; Kaiser, S.; Vyalikh, D.; Bazhenov, V.V.; et al. Extreme biomimetic approach for developing novel chitin-GeO2 nanocomposites with photoluminescent properties. Nano Res. 2015, 8, 2288–2301. [Google Scholar] [CrossRef]
- Wysokowski, M.; Motylenko, M.; Stöcker, H.; Bazhenov, V.V.; Langer, E.; Dobrowolska, A.; Czaczyk, K.; Galli, R.; Stelling, A.L.; Behm, T.; et al. An extreme biomimetic approach: Hydrothermal synthesis of β-chitin/ZnO nanostructured composites. J. Mater. Chem. B 2013, 1, 6469–6476. [Google Scholar] [CrossRef]
- Hongfeng, L.; Jia, L.; Jun, W. Synthesis of Biomorphic ZnO Using Cotton as the Biotemplate. Mater. Rev. 2008, S3. [Google Scholar]
- Han, J.; Su, H.; Xu, J.; Song, W.; Gu, Y.; Chen, Y.; Moon, W.-J.; Zhang, D. Silk-mediated synthesis and modification of photoluminescent ZnO nanoparticles. J. Nanopart. Res. 2012, 14, 726. [Google Scholar] [CrossRef]
- Shubha, P.; Gowda, M.L.; Namratha, K.; Shyamsunder, S.; Manjunatha, H.B.; Byrappa, K. Ex-situ fabrication of ZnO nanoparticles coated silk fiber for surgical applications. Mater. Chem. Phys. 2019, 231, 21–26. [Google Scholar] [CrossRef]
- Gulrajani, M.L.; Gupta, D.; Periyasamy, S.; Muthu, S.G. Preparation and application of silver nanoparticles on silk for imparting antimicrobial properties. J. Appl. Polym. Sci. 2008, 108, 614–623. [Google Scholar] [CrossRef]
- Gore, P.M.; Naebe, M.; Wang, X.; Kandasubramanian, B. Progress in silk materials for integrated water treatments: Fabrication, modification and applications. Chem. Eng. J. 2019, 374, 437–470. [Google Scholar] [CrossRef]
- Zheng, K.; Zhong, J.; Qi, Z.; Ling, S.; Kaplan, D.L. Isolation of Silk Mesostructures for Electronic and Environmental Applications. Adv. Funct. Mater. 2018, 28, 1806380. [Google Scholar] [CrossRef]
- Tomczak, M.M.; Gupta, M.K.; Drummy, L.F.; Rozenzhak, S.M.; Naik, R.R. Morphological control and assembly of zinc oxide using a biotemplate. Acta Biomater. 2009, 5, 876–882. [Google Scholar] [CrossRef] [PubMed]
- Bertilsson, S.; Widenfalk, A. Photochemical degradation of PAHs in freshwaters and their impact on bacterial growth–influence of water chemistry. Hydrobiologia 2002, 469, 23–32. [Google Scholar] [CrossRef]
- Naushad, M.; Al Othman, Z.A.; Awual, M.R.; Alfadul, S.M.; Ahamad, T. Adsorption of rose Bengal dye from aqueous solution by amberlite Ira-938 resin: Kinetics, isotherms, and thermodynamic studies. Desalin. Water Treat. 2016, 57, 13527–13533. [Google Scholar] [CrossRef]
- Cai, L.; Shao, H.; Hu, X.; Zhang, Y. Reinforced and Ultraviolet Resistant Silks from Silkworms Fed with Titanium Dioxide Nanoparticles. ACS Sustain. Chem. Eng. 2015, 3, 2551–2557. [Google Scholar] [CrossRef]
- Djelloul, A.; Bouzid, K.; Guerrab, F. Role of Substrate Temperature on the Structural and Morphological Properties of ZnO Thin Films Deposited by Ultrasonic Spray Pyrolysis. Turk. J. Phys. 2008, 32, 49–58. [Google Scholar]
- Silvestri, D.; Mikšíček, J.; Wacławek, S.; Torres-Mendieta, R.; Padil, V.V.T.; Černík, M. Production of electrospun nanofibers based on graphene oxide/gum Arabic. Int. J. Biol. Macromol. 2019, 124, 396–402. [Google Scholar] [CrossRef]
- Cao, T.-T.; Zhang, Y.-Q. Processing and characterization of silk sericin from Bombyx mori and its application in biomaterials and biomedicines. Mater. Sci. Eng. C Mater. Biol. Appl. 2016, 61, 940–952. [Google Scholar] [CrossRef] [PubMed]
- Dong, Q.; Su, H.; Zhang, D. In situ depositing silver nanoclusters on silk fibroin fibers supports by a novel biotemplate redox technique at room temperature. J. Phys. Chem. B 2005, 109, 17429–17434. [Google Scholar] [CrossRef] [PubMed]
- Zhang, H.; Li, L.-L.; Dai, F.-Y.; Zhang, H.-H.; Ni, B.; Zhou, W.; Yang, X.; Wu, Y.-Z. Preparation and characterization of silk fibroin as a biomaterial with potential for drug delivery. J. Transl. Med. 2012, 10, 117. [Google Scholar] [CrossRef] [PubMed]
- Koutu, V.; Shastri, L.; Malik, M.M. Effect of NaOH concentration on optical properties of zinc oxide nanoparticles. Mater. Sci.-Pol. 2016, 34, 819–827. [Google Scholar] [CrossRef]
- Khaghanpour, Z.; Naghibi, S. Perforated ZnO nanoflakes as a new feature of ZnO achieved by the hydrothermal-assisted sol–gel technique. J. Nanostructure Chem. 2017, 7, 55–59. [Google Scholar] [CrossRef]
- Assi, N. Synthesis of ZnO-nanoparticles by microwave assisted sol-gel method and its role in photocatalytic degradation of food dye Tartrazine (Acid Yellow 23). Int. J. Nano Dimens. 2017, 8, 241–249. [Google Scholar]
- Hammad, T.M.; Salem, J.K.; Harrison, R.G. Synthesis, Characterizaton, and Optical Properties of Y-Doped ZnO Nanaoparticles. Nano 2009, 4, 225–232. [Google Scholar] [CrossRef]
- Liqiang, J.; Yichun, Q.; Baiqi, W.; Shudan, L.; Baojiang, J.; Libin, Y.; Wei, F.; Honggang, F.; Jiazhong, S. Review of photoluminescence performance of nano-sized semiconductor materials and its relationships with photocatalytic activity. Sol. Energy Mater. Sol. Cells 2006, 90, 1773–1787. [Google Scholar] [CrossRef]
- Lair, A.; Ferronato, C.; Chovelon, J.-M.; Herrmann, J.-M. Naphthalene degradation in water by heterogeneous photocatalysis: An investigation of the influence of inorganic anions. J. Photochem. Photobiol. Chem. 2008, 193, 193–203. [Google Scholar] [CrossRef]
- Jing, L.; Chen, B.; Zhang, B.; Zheng, J.; Liu, B. Naphthalene degradation in seawater by UV irradiation: The effects of fluence rate, salinity, temperature and initial concentration. Mar. Pollut. Bull. 2014, 81, 149–156. [Google Scholar] [CrossRef]
- Xu, F.; Yuan, Z.-Y.; Du, G.-H.; Ren, T.-Z.; Bouvy, C.; Halasa, M.; Su, B.-L. Simple approach to highly oriented ZnO nanowire arrays: Large-scale growth, photoluminescence and photocatalytic properties. Nanotechnology 2006, 17, 588–594. [Google Scholar] [CrossRef]
- Singh, P.; Mondal, K.; Sharma, A. Reusable electrospun mesoporous ZnO nanofiber mats for photocatalytic degradation of polycyclic aromatic hydrocarbon dyes in wastewater. J. Colloid Interface Sci. 2013, 394, 208–215. [Google Scholar] [CrossRef] [PubMed]
- Chakraborty, J.N. 15-Dyeing with acid dye. In Fundamentals and Practices in Colouration of Textiles; Chakraborty, J.N., Ed.; Woodhead Publishing India: New Delhi, Indian, 2014; pp. 177–186. [Google Scholar]
- Kumar Gupta, V.; Mittal, A.; Jhare, D.; Mittal, J. Batch and bulk removal of hazardous colouring agent Rose Bengal by adsorption techniques using bottom ash as adsorbent. RSC Adv. 2012, 2, 8381–8389. [Google Scholar] [CrossRef]
- Vinuth, M.; Naik, H.S.B. Rapid Removal of Hazardous Rose Bengal Dye Using Fe(III)– Montmorillonite as an Effective Adsorbent in Aqueous Solution. J. Environ. Anal. Toxicol. 2016, 06. [Google Scholar] [CrossRef]
- Dimapilis, E.A.S.; Hsu, C.-S.; Mendoza, R.M.O.; Lu, M.-C. Zinc oxide nanoparticles for water disinfection. Sustain. Environ. Res. 2018, 28, 47–56. [Google Scholar] [CrossRef]
- Chakra, C.H.S.; Rajendar, V.; Rao, K.V.; Kumar, M. Enhanced antimicrobial and anticancer properties of ZnO and TiO2 nanocomposites. 3 Biotech 2017, 7, 89. [Google Scholar] [CrossRef]
- Tiwari, V.; Mishra, N.; Gadani, K.; Solanki, P.S.; Shah, N.A.; Tiwari, M. Mechanism of Anti-bacterial Activity of Zinc Oxide Nanoparticle Against Carbapenem-Resistant Acinetobacter baumannii. Front. Microbiol. 2018, 9. [Google Scholar] [CrossRef]

© 2020 by the authors. Licensee MDPI, Basel, Switzerland. This article is an open access article distributed under the terms and conditions of the Creative Commons Attribution (CC BY) license (http://creativecommons.org/licenses/by/4.0/).
Share and Cite
Rao, K.J.; Korumilli, T.; KP, A.; Wacławek, S.; Černík, M.; Padil, V.V.T. Development of ZnO Nanoflake Type Structures Using Silk Fibres as Template for Water Pollutants Remediation. Polymers 2020, 12, 1151. https://doi.org/10.3390/polym12051151
Rao KJ, Korumilli T, KP A, Wacławek S, Černík M, Padil VVT. Development of ZnO Nanoflake Type Structures Using Silk Fibres as Template for Water Pollutants Remediation. Polymers. 2020; 12(5):1151. https://doi.org/10.3390/polym12051151
Chicago/Turabian StyleRao, K. Jagajjanani, Tarangini Korumilli, Akshaykumar KP, Stanisław Wacławek, Miroslav Černík, and Vinod V. T. Padil. 2020. "Development of ZnO Nanoflake Type Structures Using Silk Fibres as Template for Water Pollutants Remediation" Polymers 12, no. 5: 1151. https://doi.org/10.3390/polym12051151
APA StyleRao, K. J., Korumilli, T., KP, A., Wacławek, S., Černík, M., & Padil, V. V. T. (2020). Development of ZnO Nanoflake Type Structures Using Silk Fibres as Template for Water Pollutants Remediation. Polymers, 12(5), 1151. https://doi.org/10.3390/polym12051151

